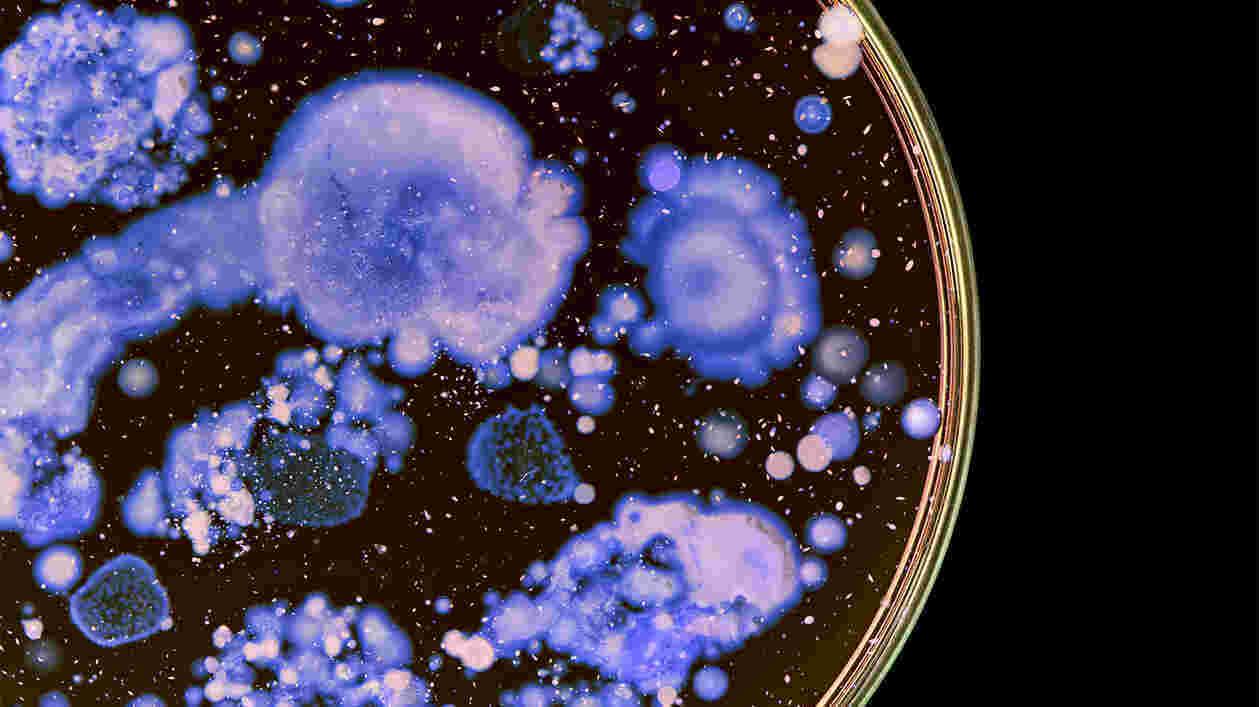

Topics
Veterinary Medicine

May 12, 2026
UMD Research Changes Lives: Scientist Analyzes Bloodsuckers’ Immune Systems for Disease-Prevention Strategies

December 11, 2025
Pines, Nelson, Raghavan Honored for ‘Translating Research Into Products and Services That Improve Lives’

September 22, 2025
Early Antiviral Treatment Can Return Some Pets to Full Health, Protect Against Reinfection

May 09, 2025
20-Year Review Underscores Need for Better Surveillance to Protect Cats, Humans

April 30, 2025
On the Farm and in the Lab, Researchers Are Fighting a Virus That’s Pushing Up Food Prices and Threatening a New Pandemic

April 14, 2025
With USDA Award, UMD Researcher Aims to Develop Nasal Vaccine Against H5N1 in Cows

April 03, 2025
NIH Grant Supports Multi-institutional Campaign Combatting Pest’s Ability to Harbor, Transmit Bacteria

February 06, 2025
Faculty Pursuing Collaborative Work on Pressing Issues Awarded $150K
November 18, 2024
How UMD Researchers Combat Antimicrobial Resistance in Human Health, Agriculture and Industry

June 14, 2024
Virus Can Infect and Kill Domestic Felines, Which Could Put Humans at Risk

April 03, 2024
After Human Case Confirmed, UMD Expert Warns: Mammal-to-Mammal Infection Require More Safeguards

February 16, 2024
University of Maryland, College Park Awarded 59 Patents in 2023

January 25, 2024
VetMed Researcher Investigating New Canine Respiratory Disease Calls for Awareness, Quick Treatment

October 30, 2023
UMD Experts Weigh in on the Creatures Haunting Our Neighborhoods This Halloween

February 14, 2023
Targeting Proteins in MRSA Might Render ‘Superbug’ Harmless, Prevent Antibiotic Resistance

January 27, 2023
New Discoveries Offer Hope in Fight Against Lyme and Other Diseases